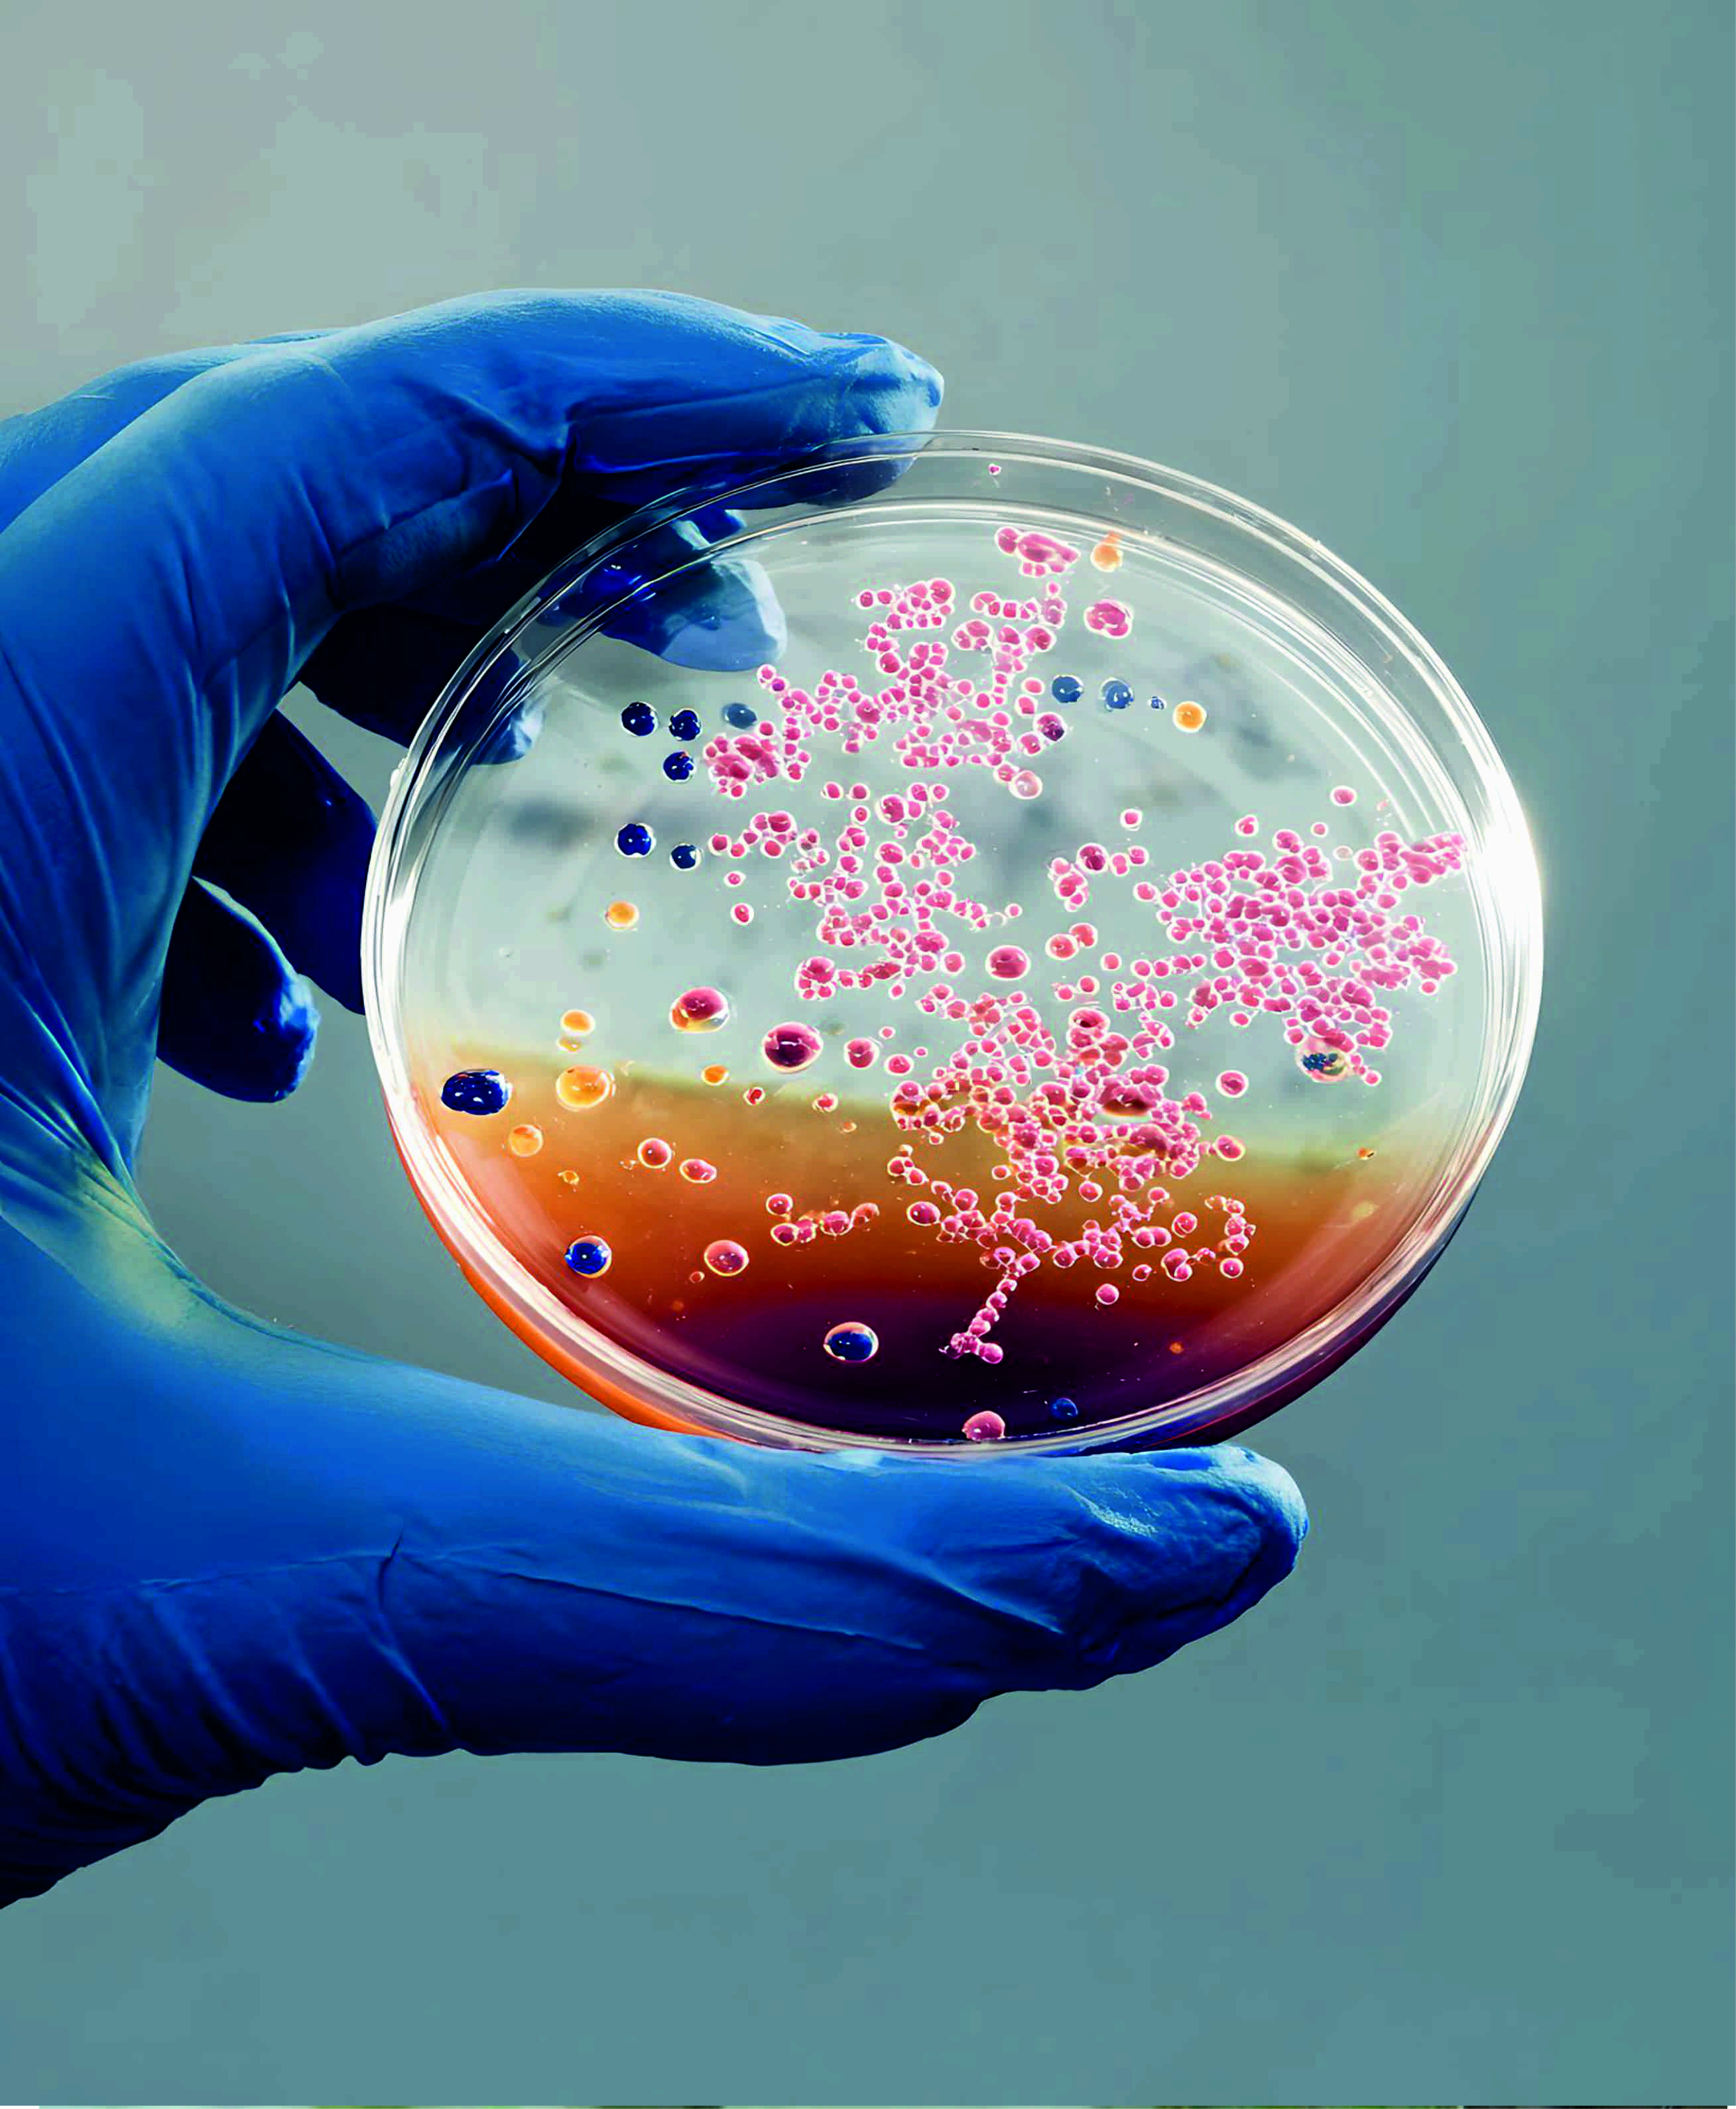

Welcome to Gene Arch!
About Us
Welcome to Gene Arch
Gene Arch Biosciences delivers a wide spectrum of genomic services designed to support diverse research requirements. With one of the most extensive portfolios of sequencing options available, spanning human, plant, animal, and microbial studies, the organization offers innovative, cost-effective, and dependable solutions for a broad range of genomic challenges faced by researchers and collaborators. Its facilities are equipped with both next-generation and Sanger sequencing platforms, enabling exceptionally high sequencing throughput. Committed to excellence,
Gene Arch Biosciences maintains rigorous standards in sample preparation, experimental design, and tailored bioinformatics analysis, ensuring fast, precise, and reliable sequencing outcomes for all types of genomic research.